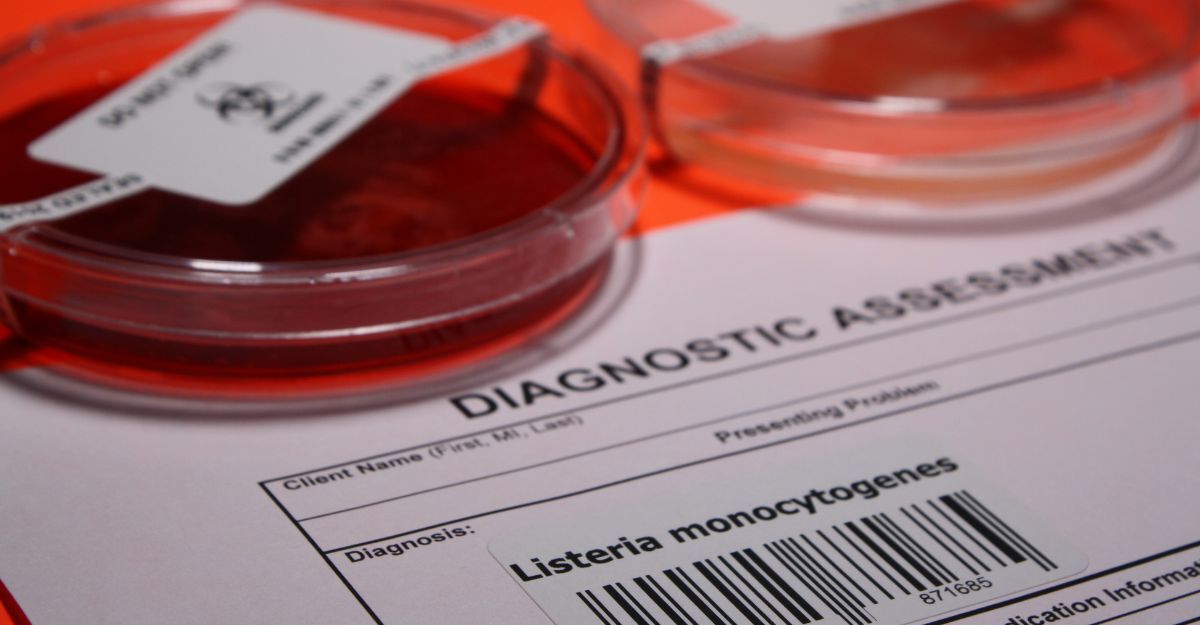
Una cartella clinica

I casi di listeriosi nell’Unione Europea hanno raggiunto il picco più alto dal 2007, evidenziando un trend preoccupante per la salute pubblica: Campilobatteriosi e salmonellosi continuano a essere le malattie zoonotiche più diffuse, mentre le epidemie alimentari mostrano un lieve calo.
Vediamo insieme cosa emerge dal rapporto annuale sulle zoonosi.
Il report
Il Centro europeo per la prevenzione e il controllo delle malattie (Ecdc) e l’Ente europeo per la sicurezza alimentare (Efsa) evidenziano, tramite il rapporto annuale One Health sulle zoonosi (infezioni che possono essere trasmesse direttamente o indirettamente tra gli animali e l'uomo) come i casi di listeriosi nell’Unione Europea abbiano toccato il picco più alto dal 2007.
Facendo un focus sui disturbi più presenti, campilobatteriosi e salmonellosi sono le malattie zoonotiche più diffuse – mentre le epidemie alimentari sono in lieve calo.
I casi di Listeriosi (2.952), in particolare, sono aumentati costantemente dal 2019 al 2023 anche a causa dell’aumento della popolazione europea – si segnala che oltre il 21% dei cittadini comunitari ha più di 65 anni.
Questa fascia d’età, infatti, è più vulnerabile a sintomi gravi, complice anche la maggiore prevalenza di malattie croniche legate all’età.
Gli alimenti pronti al consumo che si dimostrano fonte principale di infezione sono:
- salmone affumicato;
- latticini;
- frutti di bosco congelati;
- prodotti a base di carne.
Nel 2023 sono stati registrati 148.181 casi di campilobatteriosi, numero in crescita rispetto al 2022 (quando furono 139.225): questo dato conferma come si tratti dell’infezione zoonotica più segnalata nell’UE.
Al secondo posto è possibile trovare la salmonellosi con 77.486 casi, anch’essa in aumento rispetto ai 65.478 dell’anno precedente. A questo dato si aggiunge che solo 15 Stati membri, insieme al Regno Unito (Irlanda del Nord), hanno raggiunto tutti gli obiettivi di riduzione della Salmonella nel pollame – un numero in calo rispetto ai 19 Stati conformi nel 2022.
Epidemie alimentari: focus su uova e pollame
Se da una parte è stata registrata una lieve flessione delle epidemie alimentari complessive nel 2023 (5.691 segnalazioni), dall’altra il numero di ricoveri e decessi è aumentato, toccando i livelli più alti dell’ultimo decennio.
Le uova, i prodotti a base di uova e la carne di pollo sono tra le principali fonti di contaminazione – confermando che la causa principale di queste epidemie è la Salmonella.
L’uso del sequenziamento dell’intero genoma ha permesso di affinare il monitoraggio, migliorando la capacità di identificare le epidemie nei Paesi che hanno adottato questa tecnologia.
L’Efsa ha introdotto strumenti innovativi per rendere i dati più accessibili e fruibili, tra cui mappe narrative e dashboard interattive per visualizzare le informazioni su 14 patogeni zoonotici e epidemie alimentari.
Per esempio, nuove mappe sono dedicate a malattie come febbre Q, rabbia, toxoplasmosi e virus del Nilo occidentale.
I dati indicano che una piccola percentuale di alimenti pronti al consumo supera ancora i limiti di sicurezza per Listeria monocytogenes, con le salsicce fermentate che mostrano i livelli più alti di contaminazione (0,78%).
La lotta contro le malattie zoonotiche richiede dunque non solo vigilanza, ma anche innovazione e collaborazione tra Paesi, per garantire che alimenti e popolazione siano sempre più protetti.